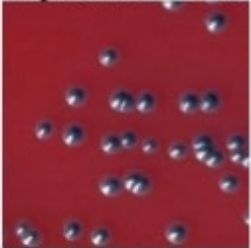
Flashcard 2 image
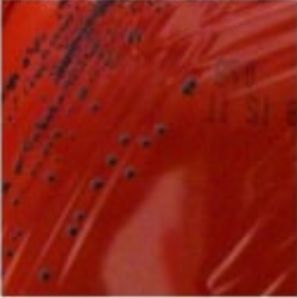
Flashcard 3 image

Bacteriology — Flashcards

On this page
Which subtype of diphtheria bacilli shows 'poached egg' colonies (flat with central elevation)? _____
School of fish/railroad track appearance on Gram stain is suggestive of _____

Which subtype of diphtheria bacilli shows 'frog egg' colonies (dark centre, light margins)? _____
Miyagawa bodies are seen in _____

Which bacteria is seen cultured from the vagina below? _____

Bipolar staining (safety pin appearance) is shown by: _____
Hint: 6

_____ causes yaws
toxins of tetanus are _____
typhoid bacilli reside primarily in _____ in chronic carriers
Q fever is caused by _____
Study by Chapter
Staphylococci
Flashcards
Streptococci and Enterococci
Flashcards
Neisseria and Moraxella
Flashcards
Corynebacterium and Listeria
Flashcards
Bacillus and Clostridium
Flashcards
Enterobacteriaceae
Flashcards
Vibrio, Aeromonas, and Plesiomonas
Flashcards
Pseudomonas and Related Bacteria
Flashcards
Haemophilus and HACEK Group
Flashcards
Bordetella and Brucella
Flashcards
Mycobacteria
Flashcards
Spirochetes
Flashcards
About Bacteriology Flashcards for NEET-PG
These Bacteriology flashcards are designed for NEET-PG Microbiology preparation, using active recall to help you retain high-yield concepts, clinical correlations, and commonly tested facts. Each card prompts you to retrieve information from memory rather than passively reviewing notes, which research shows leads to significantly better exam performance.
The 348 cards in this deck cover the most important topics in Bacteriology, including key mechanisms, diagnostic criteria, treatment protocols, and clinical pearls that frequently appear in NEET-PG examinations. Cards are organised by chapter so you can focus on specific areas or work through the entire topic systematically.
For personalised spaced repetition scheduling that adapts to your performance, unlimited flashcards, and detailed progress analytics, download the Oncourse app.
Frequently Asked Questions
Are Bacteriology flashcards free on Oncourse?
How do flashcards help with NEET-PG preparation?
How many Bacteriology flashcards are available?
Can I study Bacteriology flashcards by chapter?
What topics do these Microbiology flashcards cover?
Want unlimited flashcards?
Get full access to all flashcards, spaced repetition, and progress tracking.
Start For Free